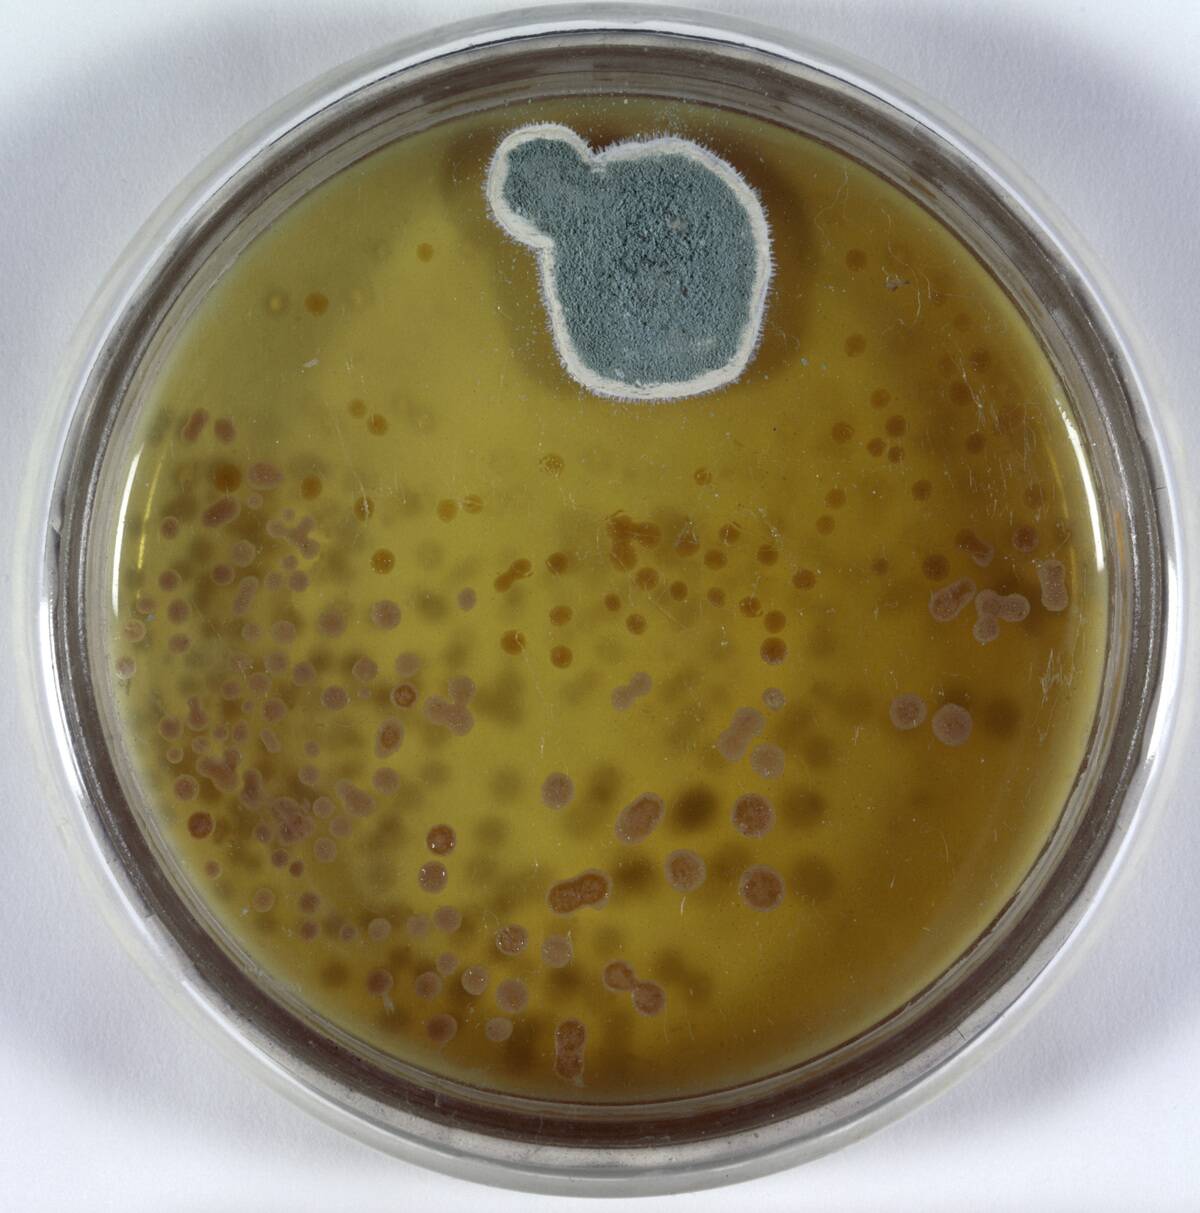
Model of culture dish and penicillin mould. Creator: Unknown
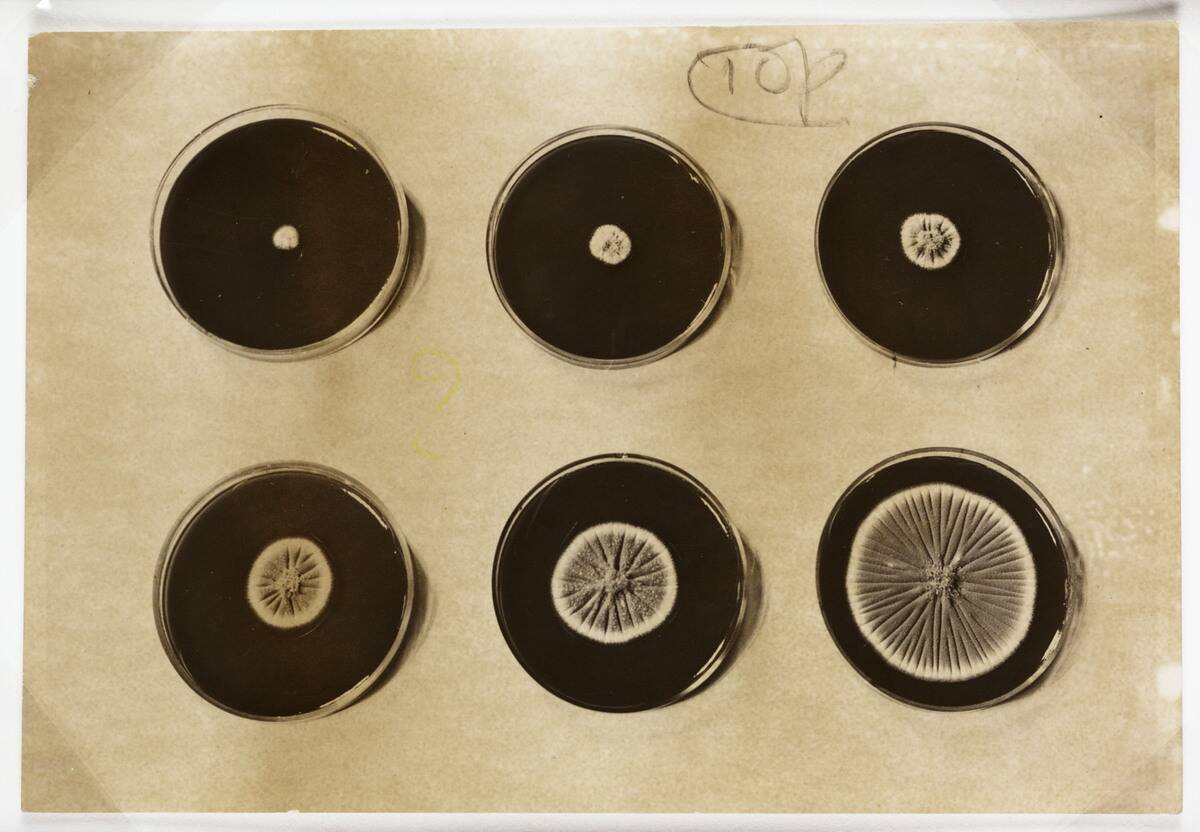
Penicillin cultures, 1943

Learn about the scientists who developed the first penicillin
Penicillin, a relatively humble mold, revolutionized medicine and became a cornerstone of modern healthcare. Its discovery is hailed as one of the greatest medical breakthroughs of the 20th century. Before penicillin, bacterial infections often led to serious complications or death.
This miracle drug changed that narrative, ushering in an era where doctors could effectively treat infections, greatly reducing mortality rates. Its journey from a simple lab accident to a global medical marvel is nothing short of fascinating.
The Accidental Discovery: A Stroke of Luck

The story of penicillin’s discovery begins with a fortunate accident. In 1928, Alexander Fleming returned from a holiday to find that a mold had contaminated his Petri dishes. Rather than discarding them, he noticed something peculiar: The bacteria surrounding the mold had been destroyed.
This serendipitous observation led to the identification of penicillin, which would later save countless lives. Fleming’s keen eye and curiosity turned a simple mistake into a groundbreaking medical advancement.
Meet Alexander Fleming: The Man Behind the Mold

Alexander Fleming, born in Scotland in 1881, was a humble bacteriologist with a penchant for untidiness in his laboratory. His work at St. Mary’s Hospital in London allowed him to blend his interest in microbiology with his dedication to improving human health.
Known for his modesty, Fleming often credited chance for his discovery, emphasizing the importance of observation in scientific progress. Despite his reserved nature, his contributions to medicine have cemented his legacy as a pioneer in antibiotics.
Fleming’s Eureka Moment: The Petri Dish Story

Fleming’s eureka moment occurred when he noticed a halo of inhibition around a colony of mold in his Petri dishes. This mold, later identified as Penicillium notatum (and then Penicillium rubens), was effectively killing surrounding bacteria.
Although he recognized its potential, he struggled to purify, stabilize, and isolate the compound for practical use. Nevertheless, this discovery laid the groundwork for future researchers to develop it into a life-saving drug.
Early Life of Alexander Fleming: From Farm to Fame

Growing up on a farm in rural Scotland, Fleming developed a strong work ethic and curiosity about the natural world. These early experiences nurtured his interest in biology and laid the foundation for his future scientific endeavors.
Despite his rural beginnings, Fleming’s academic prowess earned him a scholarship to Kilmarnock Academy and later, St. Mary’s Hospital Medical School in London. His journey from farm boy to celebrated scientist is a testament to his determination and passion for discovery.
Fleming’s Academic Journey: The Path to Discovery

Fleming’s academic journey was marked by both opportunity and perseverance. After completing his studies at St. Mary’s Hospital, he joined the Inoculation Department, where he honed his skills in bacteriology.
His work on antiseptics during World War I highlighted the need for better treatments for bacterial infections, fueling his quest for new antibiotics. Fleming’s relentless pursuit of knowledge and innovation set the stage for his eventual discovery of penicillin, changing the course of medical history.
Challenges in the Early Days: Skepticism and Struggles
Despite the promise of penicillin, Fleming faced skepticism from the scientific community. Many doubted its potential, citing the difficulties in extracting and stabilizing the compound.
Fleming’s own attempts to develop penicillin for medical use were met with limited success, as he lacked the resources and technology to mass-produce it. It wasn’t until the involvement of other researchers that penicillin’s true potential was realized, overcoming initial doubts and challenges to become a medical staple.
Howard Florey and Ernst Boris Chain: Enter the Collaborators

The collaboration of Howard Florey and Ernst Boris Chain was pivotal in transforming penicillin from a laboratory novelty into a mass-produced drug. Florey, an Australian pathologist, and Chain, a German biochemist, joined forces at the University of Oxford in the late 1930s.
Together, they developed a method to extract and purify penicillin in sufficient quantities for clinical testing, overcoming the technical challenges that had hindered Fleming. Their work laid the foundation for penicillin’s widespread use.
Florey and Chain’s Background: From Humble Beginnings

Florey and Chain’s backgrounds were as diverse as they were inspiring. Florey hailed from Adelaide, Australia, where a passion for science led him to study medicine. Chain, on the other hand, fled from Nazi Germany, bringing his expertise in chemistry to the UK.
Their shared determination and complementary skills proved invaluable in the quest to harness the power of penicillin. Their collaboration not only advanced medical science but also highlighted the power of teamwork in overcoming adversity.
The Oxford Team: A Dynamic Duo with a Mission
At Oxford, Florey and Chain assembled a talented team dedicated to unlocking penicillin’s potential. Their mission was clear: To develop a viable method for mass production.
With limited resources, the team employed innovative techniques to purify and stabilize penicillin, paving the way for its use in treating bacterial infections. Their tireless efforts were rewarded when penicillin demonstrated remarkable effectiveness in clinical trials, proving its potential as a life-saving antibiotic and cementing their place in medical history.
Scaling Up Production: From Laboratory to Large-Scale

Scaling up penicillin production was a monumental challenge. The Oxford team faced numerous technical and logistical hurdles in their quest to produce penicillin on a large scale. Collaborating with pharmaceutical companies, they developed fermentation techniques to increase yield.
By 1943, these efforts bore fruit, and penicillin was being produced in significant quantities. This achievement marked a turning point in the fight against bacterial infections, as the drug became more widely available to those in need.
Overcoming Obstacles: The War Effort and Penicillin

The outbreak of World War II added urgency to the penicillin project. The Allied forces needed an effective treatment for infected wounds on the battlefield, and penicillin offered an ideal solution.
Despite wartime shortages and challenges, the Oxford team and their partners ramped up production. The U.S. government declared penicillin a wartime priority, leading to increased funding and resources. By D-Day in 1944, penicillin was available to treat wounded soldiers, proving its impact on the war effort.
Penicillin’s Impact on WWII: Saving Lives on the Frontline

Penicillin’s role in World War II cannot be overstated. Used extensively to treat infections among Allied troops, it significantly reduced mortality rates from infected wounds and surgical complications. Its availability on the frontlines meant that soldiers who might have succumbed to infections were instead able to recover and return to duty.
This not only saved countless lives but also boosted morale among the troops. Penicillin’s success during the war underscored its importance and solidified its place in medical history.
The 1945 Nobel Prize: Recognition at Last

In 1945, Alexander Fleming, Howard Florey, and Ernst Boris Chain were jointly awarded the Nobel Prize in Physiology or Medicine for their roles in the discovery and development of penicillin. This recognition was a testament to their individual contributions and collective achievements in revolutionizing medicine.
The Nobel Committee’s acknowledgment highlighted the significance of penicillin as a breakthrough in the treatment of bacterial infections, cementing the trio’s legacy as pioneers in the field of antibiotics.
The Legacy of Penicillin: A Medical Revolution

Penicillin’s legacy extends far beyond its initial success. It spurred the development of a new class of antibiotics, transforming the treatment of bacterial infections worldwide. Its impact on public health is immeasurable, drastically reducing deaths from diseases such as pneumonia and syphilis.
The success of penicillin also paved the way for further research into antibiotic resistance, an ongoing challenge in modern medicine. Today, penicillin remains a symbol of scientific innovation and its profound impact on human health.
Modern-Day Penicillin: Innovations and Improvements

Since its discovery, penicillin has undergone numerous innovations to improve its efficacy and broaden its uses. Modern derivatives, known as semi-synthetic penicillins, are designed to combat a wider range of bacteria and overcome resistance.
Advances in biotechnology have also enhanced production methods, making penicillin more accessible around the world. Despite the rise of antibiotic resistance, penicillin and its derivatives remain critical tools in the medical arsenal, demonstrating the enduring relevance of this groundbreaking discovery.
Fleming, Florey, and Chain: Their Lives Beyond Penicillin

Beyond penicillin, Fleming, Florey, and Chain pursued diverse interests. Fleming continued his research in bacteriology and was knighted in 1944 for his contributions. Florey became a key figure in medical education and was appointed to the Order of Merit. Chain focused on biochemistry and worked on other antibiotics.
Their collective legacy extends beyond their scientific achievements, inspiring future generations of researchers and highlighting the importance of curiosity, collaboration, and perseverance in scientific discovery.
